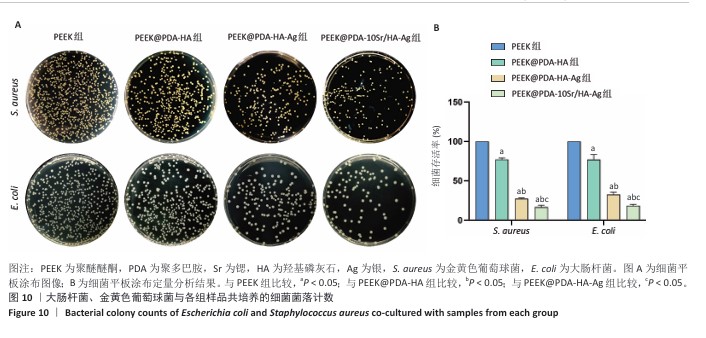

[1] HE M, HUANG Y, XU H, et al. Modification of polyetheretherketone implants: From enhancing bone integration to enabling multi-modal therapeutics. Acta Biomater. 2021;129:18-32.
[2] AREVALO S, ARTHURS C, MOLINA MIE, et al. An overview of the tribological and mechanical properties of PEEK and CFR-PEEK for use in total joint replacements. J Mech Behav Biomed Mater. 2023;145:105974.
[3] LIU Y, FANG M, ZHAO R, et al. Clinical Applications of Polyetheretherketone in Removable Dental Prostheses: Accuracy, Characteristics, and Performance. Polymers (Basel). 2022;14(21):4615.
[4] YU D, LEI X, ZHU H. Modification of polyetheretherketone (PEEK) physical features to improve osteointegration. J Zhejiang Univ-Sci B. 2022;23(3):189-203.
[5] CHEN T, JINNO Y, ATSUTA I, et al. Current surface modification strategies to improve the binding efficiency of emerging biomaterial polyetheretherketone (PEEK) with bone and soft tissue: A literature review. J Prosthodont Res. 2022; 67(3):337-347.
[6] CHEN M, QIAO Y, YU L, et al. A microenvironment responsive polyetheretherketone implant with antibacterial and osteoimmunomodulatory properties facilitates osseointegration. Bioact Mater. 2025;43:273-291.
[7] SUN Y, LIU X, TAN J, et al. Strontium ranelate incorporated 3D porous sulfonated PEEK simulating MC3T3-E1 cell differentiation. Regen Biomater. 2021;8(1): rbaa043.
[8] MANZOOR F, GOLBANG A, DIXON D, et al. 3D Printed Strontium and Zinc Doped Hydroxyapatite Loaded PEEK for Craniomaxillofacial Implants. Polymers (Basel). 2022;14(7):1376.
[9] YANG X, XIONG S, ZHOU J, et al. Coating of manganese functional polyetheretherketone implants for osseous interface integration. Front Bioeng Biotechnol. 2023;11:1182187.
[10] LIU X, GAN K, LIU H, et al. Antibacterial properties of nano-silver coated PEEK prepared through magnetron sputtering. Dent Mater. 2017;33(9):e348-e360.
[11] YILMAZ B, ALSHEMARY AZ, EVIS Z. Co-doped hydroxyapatites as potential materials for biomedical applications. Microchem J. 2019;144:443-453.
[12] YU Y, LIU K, WEN Z, et al. Double-edged effects and mechanisms of Zn2+ microenvironments on osteogenic activity of BMSCs: osteogenic differentiation or apoptosis. RSC Adv. 2020;10(25):14915-14927.
[13] BERNHARDT A, SCHAMEL M, GBURECK U, et al. Osteoclastic differentiation and resorption is modulated by bioactive metal ions Co2+, Cu2+ and Cr3+ incorporated into calcium phosphate bone cements. PLoS One. 2017;12(8):e0182109.
[14] 齐军强,郭超,牛东阳,等.金属离子掺杂羟基磷灰石骨修复材料的特性及应用[J].中国组织工程研究,2023,27(21):3415-3422.
[15] CUI X, ZHANG Y, WANG J, et al. Strontium modulates osteogenic activity of bone cement composed of bioactive borosilicate glass particles by activating Wnt/β-catenin signaling pathway. Bioact Mater. 2020;5(2):334-347.
[16] SHENG X, LI C, WANG Z, et al. Advanced applications of strontium-containing biomaterials in bone tissue engineering. Mater Today Bio. 2023;20:100636.
[17] GRAZIANI G, GHEZZI D, BOI M, et al. Ionized jet deposition of silver nanostructured coatings: Assessment of chemico-physical and biological behavior for application in orthopedics. Biomater Adv. 2024;159:213815.
[18] GARCÍA I, TROBAJO C, AMGHOUZ Z, et al. Ag- and Sr-enriched nanofibrous titanium phosphate phases as potential antimicrobial cement and coating for a biomedical alloy. Mater Sci Eng C. 2021;126:112168.
[19] KOKUBO T, TAKADAMA H. How useful is SBF in predicting in vivo bone bioactivity? Biomaterials. 2006;27(15):2907-2915.
[20] GAO C, WANG Y, HAN F, et al. Antibacterial activity and osseointegration of silver-coated poly(ether ether ketone) prepared using the polydopamine-assisted deposition technique. J Mater Chem B. 2017;5(47):9326-9336.
[21] YANG X, WANG Q, ZHANG Y, et al. A dual-functional PEEK implant coating for anti-bacterial and accelerated osseointegration. Colloids Surf B Biointerfaces. 2023;224:113196.
[22] HAO Y, SHI C, ZHANG Y, et al. The research status and future direction of polyetheretherketone in dental implant —A comprehensive review. Dent Mater J. 2024;43(5):609-620.
[23] LI D, LI Y, SHRESTHA A, et al. Effects of Programmed Local Delivery from a Micro/Nano‐Hierarchical Surface on Titanium Implant on Infection Clearance and Osteogenic Induction in an Infected Bone Defect. Adv Healthc Mater. 2019;8(11):1900002.
[24] ARCIOLA CR, CAMPOCCIA D, EHRLICH GD, et al. Biofilm-Based Implant Infections in Orthopaedics. Adv Exp Med Biol. 2015;830:29-46.
[25] FU K, YANG LL, GAO N, et al. Modified five times simulated body fluid for efficient biomimetic mineralization. Heliyon. 2024;10(12):e32850.
[26] KOKUBO T, YAMAGUCHI S. Simulated body fluid and the novel bioactive materials derived from it. J Biomed Mater Res A. 2019;107(5):968-977.
[27] PUPO YM, LEITE LMB, SENEGAGLIA AC, et al. Effect of Hydroxyapatite Microspheres, Amoxicillin–Hydroxyapatite and Collagen–Hydroxyapatite Composites on Human Dental Pulp-Derived Mesenchymal Stem Cells. Materials (Basel). 2021;14(24):7515.
[28] HUANG Y, DING Q, HAN S, et al. Characterisation, corrosion resistance and in vitro bioactivity of manganese-doped hydroxyapatite films electrodeposited on titanium. J Mater Sci Mater Med. 2013;24(8):1853-1864.
[29] LIU L, YU F, LI L, et al. Bone marrow stromal cells stimulated by strontium-substituted calcium silicate ceramics: release of exosomal miR-146a regulates osteogenesis and angiogenesis. Acta Biomater. 2021;119:444-457.
[30] CHENG D, DING R, JIN X, et al. Strontium Ion-Functionalized Nano-Hydroxyapatite/Chitosan Composite Microspheres Promote Osteogenesis and Angiogenesis for Bone Regeneration. ACS Appl Mater Interfaces. 2023;15(16):19951-19965.
[31] LU W, ZHOU C, MA Y, et al. Improved osseointegration of strontium-modified titanium implants by regulating angiogenesis and macrophage polarization. Biomater Sci. 2022;10(9):2198-2214.
[32] GHORBANI F, ZAMANIAN A, BEHNAMGHADER A, et al. A facile method to synthesize mussel-inspired polydopamine nanospheres as an active template for in situ formation of biomimetic hydroxyapatite. Mater Sci Eng C. 2019;94: 729-739.
[33] PEETSCH A, GREULICH C, BRAUN D, et al. Silver-doped calcium phosphate nanoparticles: Synthesis, characterization, and toxic effects toward mammalian and prokaryotic cells. Colloids Surf B Biointerfaces. 2013;102:724-729.
[34] BRUNA T, MALDONADO-BRAVO F, JARA P, et al. Silver Nanoparticles and Their Antibacterial Applications. Int J Mol Sci. 2021;22(13):7202.
[35] HOU Y, XIE W, YU L, et al. Surface Roughness Gradients Reveal Topography‐Specific Mechanosensitive Responses in Human Mesenchymal Stem Cells. Small. 2020;16(10):1905422.
[36] SILVA GAF, FAOT F, DA SILVA WJ, et al. Does implant surface hydrophilicity influence the maintenance of surface integrity after insertion into low-density artificial bone? Dent Mater. 2021;37(2): e69-e84.
[37] NAKAMURA M, HORI N, ANDO H, et al. Surface free energy predominates in cell adhesion to hydroxyapatite through wettability. Mater Sci Eng C. 2016;62: 283-292.
[38] JOSE J, SULTAN S, KALARIKKAL N, et al. Fabrication and functionalization of 3D-printed soft and hard scaffolds with growth factors for enhanced bioactivity. RSC Adv. 2020;10(62):37928-37937.
[39] TSAI WB, CHEN WT, CHIEN HW, et al. Poly(dopamine) coating of scaffolds for articular cartilage tissue engineering. Acta Biomater. 2011;7(12):4187-4194.
[40] SAIDIN S, CHEVALLIER P, ABDUL KADIR MR, et al. Polydopamine as an intermediate layer for silver and hydroxyapatite immobilisation on metallic biomaterials surface. Mater Sci Eng C. 2013;33(8):4715-4724.
[41] TAVARES DDS, RESENDE CX, QUITAN MP, et al. Incorporation of strontium up to 5 Mol. (%) to hydroxyapatite did not affect its cytocompatibility. Mater Res. 2011;14(4):456-460.
[42] YUAN P, CHEN M, LU X, et al. Application of advanced surface modification techniques in titanium-based implants: latest strategies for enhanced antibacterial properties and osseointegration. J Mater Chem B. 2024;12(41):10516-10549.
[43] WANG H, ZHANG Y, ZHANG Y, et al. Activating Macrophage Continual Efferocytosis via Microenvironment Biomimetic Short Fibers for Reversing Inflammation in Bone Repair. Adv Mater. 2024;36(30):2402968.
[44] ZHAO Q, NI Y, WEI H, et al. Ion incorporation into bone grafting materials. Periodontol 2000. 2024;94(1):213-230.
[45] RAN L, LIU L, GAO J, et al. Strontium-doped hydroxyapatite and its role in osteogenesis and angiogenesis. Int J Dev Biol. 2023;67(4):137-146.
[46] MA F, ZHANG Y, HU L, et al. Strontium Laminarin polysaccharide modulates osteogenesis-angiogenesis for bone regeneration. Int J Biol Macromol. 2021; 181:452-461.
[47] PARK JE, JANG YS, SEO JM, et al. Facilitated osteogenesis of magnesium implant by coating of strontium incorporated calcium phosphate. Biointerphases. 2023;18(3):031002.
[48] HETRICK EM, SCHOENFISCH MH. Reducing implant-related infections: active release strategies. Chem Soc Rev. 2006;35(9):780.
[49] SALLÉ MR, DELUIZ D, FLETCHER P, et al. Decontamination and Repair Protocol Promotes Positive Outcomes in Implants Affected by Peri-implantitis: A Human Case Series. Int J Periodontics Restorative Dent. 2023;43(6):699-705.
[50] KUNKALEKAR RK, PRABHU MS, NAIK MM, et al. Silver-doped manganese dioxide and trioxide nanoparticles inhibit both Gram positive and Gram negative pathogenic bacteria. Colloids Surf B Biointerfaces. 2014;113:429-434.
[51] SOLGI M. Evaluation of plant-mediated Silver nanoparticles synthesis and its application in postharvest Physiology of cut Flowers. Physiol Mol Biol Plants. 2014;20(3):279-285.
[52] BAHEIRAEI N, EYNI H, BAKHSHI B, et al. Effects of strontium ions with potential antibacterial activity on in vivo bone regeneration. Sci Rep. 2021;11(1):8745. |